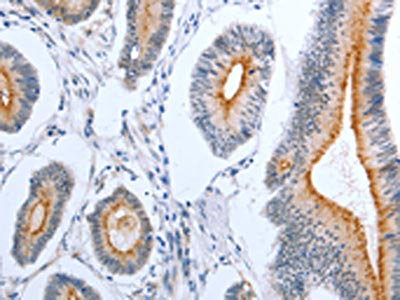

PLAUR Antibody
-
中文名稱(chēng):PLAUR兔多克隆抗體
-
貨號(hào):CSB-PA628429
-
規(guī)格:¥1100
-
圖片:
-
The image on the left is immunohistochemistry of paraffin-embedded Human lung cancer tissue using CSB-PA628429(PLAUR Antibody) at dilution 1/50, on the right is treated with fusion protein. (Original magnification: ×200)
-
The image on the left is immunohistochemistry of paraffin-embedded Human colon cancer tissue using CSB-PA628429(PLAUR Antibody) at dilution 1/50, on the right is treated with fusion protein. (Original magnification: ×200)
-
Gel: 10%SDS-PAGE, Lysate: 40 μg, Lane: A549 cells, Primary antibody: CSB-PA628429(PLAUR Antibody) at dilution 1/400, Secondary antibody: Goat anti rabbit IgG at 1/8000 dilution, Exposure time: 3 seconds
-
-
其他:
產(chǎn)品詳情
-
Uniprot No.:
-
基因名:
-
別名:CD 87 antibody; CD87 antibody; CD87 antigen antibody; MO 3 antibody; MO3 antibody; Monocyte activation antigen Mo3 antibody; Plasminogen activator receptor urokinase antibody; Plasminogen activator urokinase receptor antibody; PLAUR antibody; U PAR antibody; u plasminogen activator receptor antibody; U-PAR antibody; u-plasminogen activator receptor form 2 antibody; UPA receptor antibody; uPAR antibody; UPAR_HUMAN antibody; Urinary plasminogen activator receptor antibody; URKR antibody; Urokinase plasminogen activator receptor antibody; Urokinase plasminogen activator surface receptor antibody; urokinase-type plasminogen activator (uPA) receptor antibody
-
宿主:Rabbit
-
反應(yīng)種屬:Human
-
免疫原:Fusion protein of Human PLAUR
-
免疫原種屬:Homo sapiens (Human)
-
標(biāo)記方式:Non-conjugated
-
抗體亞型:IgG
-
純化方式:Antigen affinity purification
-
濃度:It differs from different batches. Please contact us to confirm it.
-
保存緩沖液:-20°C, pH7.4 PBS, 0.05% NaN3, 40% Glycerol
-
產(chǎn)品提供形式:Liquid
-
應(yīng)用范圍:ELISA,WB,IHC
-
推薦稀釋比:
Application Recommended Dilution ELISA 1:2000-1:5000 WB 1:500-1:2000 IHC 1:50-1:200 -
Protocols:
-
儲(chǔ)存條件:Upon receipt, store at -20°C or -80°C. Avoid repeated freeze.
-
貨期:Basically, we can dispatch the products out in 1-3 working days after receiving your orders. Delivery time maybe differs from different purchasing way or location, please kindly consult your local distributors for specific delivery time.
-
用途:For Research Use Only. Not for use in diagnostic or therapeutic procedures.
相關(guān)產(chǎn)品
靶點(diǎn)詳情
-
功能:Acts as a receptor for urokinase plasminogen activator. Plays a role in localizing and promoting plasmin formation. Mediates the proteolysis-independent signal transduction activation effects of U-PA. It is subject to negative-feedback regulation by U-PA which cleaves it into an inactive form.
-
基因功能參考文獻(xiàn):
- In acutely admitted patients with COPD, elevated PLAUR levels were associated with increased risk of mortality. PMID: 29783959
- This study shows that the D2A sequence of the UPAR induces cell growth through alphaVbeta3 integrin and EGFR. PMID: 29184982
- High expression of U-PAR is associated with breast cancer. PMID: 29893327
- suPAR is associated with the Coronary Artery Calcification score and is a risk factor for new-onset CVD in patients undergoing hemodialysis. PMID: 29734173
- Elevated baseline soluble urokinase receptor concentrations independently associate with new-onset microalbuminuria in subjects at increased risk of developing type 2 diabetes. PMID: 28091558
- suPAR levels were significantly higher Behcet's disease patients. PMID: 27171829
- To develop enzyme-resistant analogues, we applied here the Retro-Inverso (RI) approach, whereby the topology of the side chains is maintained by inverting the sequence of the peptide and the chirality of all residues. Molecular dynamics suggests that peptide RI-3 adopts the turn structure typical of uPAR-FPR1 antagonists PMID: 28465589
- results demonstrated that PLAUR induces geftinib-resistance through EGFR/p-AKT/survivin signaling pathway in gefitinib-resistant human lung adenocarcinoma cells. PLAUR could be a novel therapeutic target for gefitinib-resistant NSCLC patients. PMID: 29961070
- High Upar expression is associated with breast cancer. PMID: 28498427
- Circulating soluble uPAR levels are higher in patients with peripheral arterial disease, particularly in those with extensive atherosclerosis and are predictive of long term cardiovascular and PAD-related outcomes. PMID: 28728756
- Data confirmed PLAUR and CDH11, both targets of miR-335, to be overexpressed in gastric cancer tissues. PMID: 29075357
- Serum and urine concentration of suPAR did not different between different clinical patterns of nephrotic syndrome in children, regardless the immunosuppressive treatment used. PMID: 29775445
- the present study demonstrated that EGF induced aggressiveness of gastric cancer cells by activating epithelial to mesenchymal transition, which involved the activation of the ERK1/2 pathway and, subsequently, uPAR expression PMID: 28849196
- The results establish GDE3 as a negative regulator of the uPAR signaling network and, furthermore, highlight GPI-anchor hydrolysis as a cell-intrinsic mechanism to alter cell behavior. PMID: 28849762
- uPAR and TF could potentially be attractive targets for molecular imaging and therapy in oral squamous cell carcinoma due to high positive expression rates and tumor-specific expression patterns. High uPAR expression was significantly associated with a reduced survival. PMID: 28841839
- suPAR levels are significantly elevated in hemodialysis patients with ESRD and remain associated with adverse outcomes. PMID: 28495863
- These findings may show that presenting a high level of suPAR in migraine patients with attack and aura results to predisposition to occurring on the symptoms and that high levels of suPAR, procalcitonin and fibrinogen in patients with migraine result in neurogenic inflammation during migraine headaches. PMID: 28553881
- suPAR may be a good novel biomarker for systemic subclinical inflammation and immune activation linked to adolescent obesity. PMID: 28749394
- IFN-gamma, CXCL16 and uPAR are promising as effective biomarkers of disease activity, renal damage, and the activity of pathological lesions in systemic lupus erythematosus. PMID: 28628472
- Main associations between PLAUR (urokinase plasminogen activator receptor) single nucleotide polymorphisms (SNPs) and markers of airway remodelling, and immunohistochemical analyses PMID: 26869673
- Increased uPAR expression was detected in the derma of psoriatic lesions and in the stroma surrounding tumor cells in basal cell carcinomas. PMID: 28429105
- Plasma plasminogen activator urokinase receptor (P-suPAR) concentrations are elevated in acute alcohol pancreatitis (AAP) and correlate with the severity of the disease, suggesting P-suPAR may serve as a prognostic marker for AAP severity on admission. PMID: 27841794
- We report on the impact of bispecific targeting on the toxicity risks associated with targeting of EGFR and uPAR . Our results show that eBAT is safe and potentially effective at biologically active doses despite EGFR targeting, supporting further translation for patients with sarcomas and other EGFR-expressing malignancies. PMID: 28193671
- Improved positron emission tomography imaging of glioblastoma cancer using novel (68)Ga-labeled peptides targeting the urokinase-type plasminogen activator receptor (uPAR). PMID: 28316028
- Sera and tissues from malignant mesothelioma (MM) patients showed significantly high plasminogen activator urokinase receptor (uPAR) levels, suggesting the pathogenic role of uPAR in the tumor biology of MM. PMID: 27602956
- Levels of circulating cleaved soluble forms plasminogen activator urokinase receptor (DIIDIII-suPAR) in acute myeloid leukemia (AML) patients are higher as compared to controls and significantly decrease after the conditioning. PMID: 27517491
- Serum soluble urokinase-type plasminogen activator receptor as a serum marker of inflammatory response that leads to tissue damage and surgical complication PMID: 27759946
- Binding of uPAR to VN triggers integrin-mediated signals, which result in ERK1-2 and RAC activation, accumulation of ROS, and senescence. PMID: 28086938
- Plasma levels of intact and cleaved urokinase plasminogen activator receptor do not hold important predictive or prognostic information in men with clinically localised prostate cancer. PMID: 28607123
- This study provides novel data that elevated airway and blood uPAR is a feature of asthma and that blood uPAR is particularly related to severe, nonatopic asthma. PMID: 27624865
- uPAR and mTORC2 are components of a single cell-signaling pathway. PMID: 27777073
- Patients with high suPAR levels were more likely to have progression of their kidney disease. PMID: 28873129
- Results provide evidence that uPAR enhances malignant potential of triple-negative breast cancer by directly interacting with uPA and IGF1R. PMID: 27502396
- PLAUR to be essential for activation of Checkpoint kinase 1 (CHK1); maintenance of cell cycle arrest after DNA damage in a TP53-dependent manner; expression, nuclear import and recruitment to DNA-damage foci of RAD51 recombinase, the principal protein involved in the homologous recombination repair pathway. PMID: 27685627
- The synergy of circulating factor suPAR and APOL1 G1 or G2 on alphavbeta3 integrin activation is a mechanism for CKD. PMID: 28650456
- Patients with cancer were significantly older and had a higher burden of comorbidities and previous cancer diagnoses compared to patients who were not diagnosed with cancer. Previous cancer, C-reactive protein (CRP) and suPAR were significantly associated with newly diagnosed cancer during follow-up in multiple logistic regression analyses adjusted for age, sex and CRP PMID: 28393357
- This is the first report that PGE2 -induced uPAR expression, which stimulates invasiveness of human gastric cancer AGS cells, is mediated by the EP2 receptor-dependent Src/EGFR/JNK1/2, Erk1/2/AP-1, and Src/EGFR/JNK1/2, Erk1/2/NF-kappaB cascades. PMID: 27377703
- Studies indicate the feasibility of combining two U-PA receptor (uPAR)-targeted probes in a preclinical head and neck cancer model. PMID: 28039488
- Results suggest that soluble urokinase-type plasminogen activator receptor levels are positively correlated with severity of acute pancreatitis. PMID: 27914940
- our study indicates that suPAR increases in patients with AML and this situation is associated with poorer survival. suPAR can thus be used as a diagnostic and prognostic biomarker in AML and may help in the developing of specific therapeutic targets. PMID: 26376588
- urokinase plasminogen activator receptor has a role in incidence of venous thromboembolism PMID: 26466866
- Our study implies that both soluble UPAR and advanced echocardiography are useful diagnostic tools for identifying patients with diabetes at risk of future clinical heart disease PMID: 26951602
- The effect of LIF and uPAR on trophoblast migration and invasion was mediated by PI3K/AKT signaling pathway. PMID: 27133045
- findings showed that elevated plasma suPAR levels were independently associated with an increased risk of developing first-time myocardial infarction in an HIV-1-infected population PMID: 26365671
- Soluble urokinase plasminogen activation receptor (suPAR) is an emerging new biomarker for prognosticating cardiovascular disease PMID: 27052059
- we review the human and mouse Ly6/uPAR family gene and protein structure and genomic organization, expression, functions, and evolution, and introduce new names for novel family members PMID: 27098205
- Report presence of urokinase-type plasminogen activator receptor in seminal plasma, focusing on its interesting role as reliable and sensitive marker of inflammation for the differential diagnosis of male accessory gland inflammation. PMID: 26384478
- uPAR expression is higher in normal pregnant women than that in patients with threatened abortion. uPAR promotes trophoblast migration and invasion during embryo implantation as well as plays a role in trophoblast differentiation into syntrophoblasts. PMID: 26823748
- results show that cleaved uPAR forms are significantly increased in patients with advanced prostate cancer. PMID: 26764285
- Hypoxia enhanced the endogenous uPAR mRNA and protein expression.HIF-1 protein bound the putative HIF-1 response element on the uPAR promoter.uPAR protein expression was detected in cervical cancer but not in normal cervix or CIN. PMID: 26718775
顯示更多
收起更多
-
亞細(xì)胞定位:Cell membrane. Cell projection, invadopodium membrane.; [Isoform 1]: Cell membrane; Lipid-anchor, GPI-anchor.; [Isoform 2]: Secreted.
-
組織特異性:Expressed in neurons of the rolandic area of the brain (at protein level). Expressed in the brain.
-
數(shù)據(jù)庫(kù)鏈接:
Most popular with customers
-
-
YWHAB Recombinant Monoclonal Antibody
Applications: ELISA, WB, IHC, IF, FC
Species Reactivity: Human, Mouse, Rat
-
Phospho-YAP1 (S127) Recombinant Monoclonal Antibody
Applications: ELISA, WB, IHC
Species Reactivity: Human
-
-
-
-
-